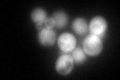
YLR179C
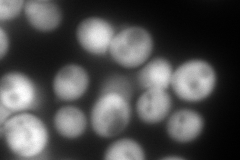
YLR179C
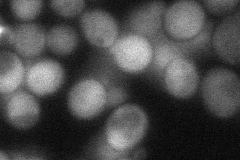
YLR179C
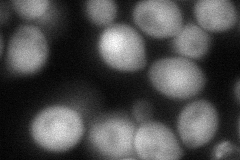
YLR179C
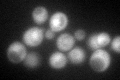
YLR179C

View description
Protein of unknown function with similarity to Tfs1p; transcription is activated by paralogous proteins Yrm1p and Yrr1p along with proteins involved in multidrug resistance; GFP-tagged protein localizes to the cytoplasm and nucleus
Localization:
Intensity:
Fold change:
Significance:
-
C’ GFP library in SD
cytosol125.71 -
N' NOP1pr-GFP in SD

cytosol357.327 -
N' TEF2pr-mCherry in SD
cytosol520.284 -
N' NATIVEpr-GFP in SD
cytosol47.9304 -
N' TEF2pr-VC and Cyto-VN in SD
cytosol93.3284 -
C’ GFP library in SD+DTT

cytosol114.470.91No -
C’ GFP library in SD+H2O2
cytosol104.650.83No -
C’ GFP library in Starvation Media

cytosol179.021.42Yes -
C’ GFP library on the background of Pup2-DaMP

cytosol -
C’ GFP library on the background of CCT mutant

cytosol110.5380.879251No
